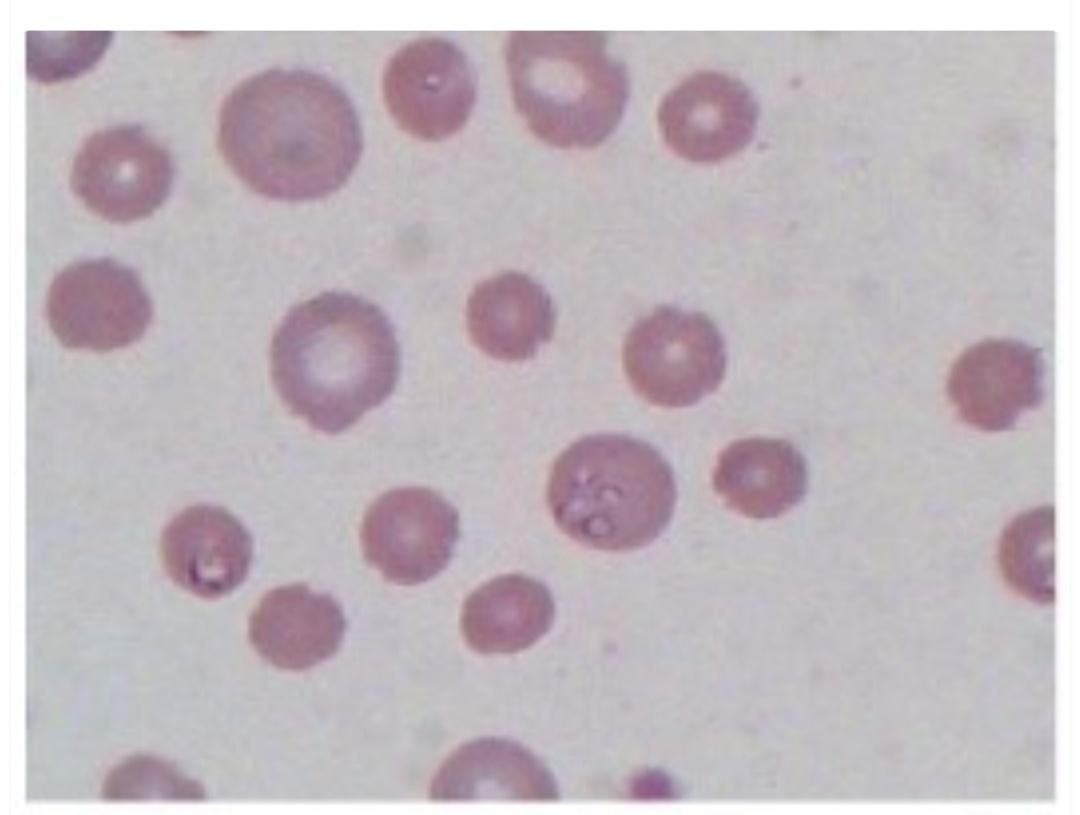
蜱虫感染巴贝斯,狗狗身上有蜱虫传染给人什么样的

夏天到了,体外驱虫又被宠物医生和宠物主人提上了日程,也开始让遛狗的宠物主人开始谨慎起来,尤其是有些得过皮肤病的狗狗,生怕一不小心就又引起狗狗的皮肤病复发,说到体外寄生虫,大家能说出来的有跳蚤、虱子、蜱虫等,因为这些大家都能接触到,而且可以直观的看到,有的宠物主人家里的狗狗也被它们伤害过,但是今天说的这个寄生虫,它虽然是有蜱虫引起,但是它却寄生于狗狗血液的红细胞内,这种寄生虫叫,犬巴贝斯虫(犬焦虫)。因为它特别小,宠物医生用显微镜才能发现它们,再加上它感染狗狗属于偶发性,所以很多宠物主人都对这个寄生虫不太熟悉,但是这个寄生虫一旦感染,即有生命危险,又难治疗,还容易复发。

什么是犬巴贝斯虫病?
犬巴贝斯虫病,俗称犬焦虫病,,是由硬蜱传播,寄生于脊椎动物红细胞中的一种血液寄生虫病,所以有的地方把这种疾病叫血液原虫病,这种疾病在蜱虫多的地方(尤其是南方地区)发生率特别高。
犬巴贝斯焦虫病原体有两种(可以理解成两种虫子,一种比较大一种比较小)
两种抗原(虫子)有什么不同呢?
- 犬巴贝斯虫 虫体较大,典型虫体为梨状,巴贝斯虫感染的狗狗,很大一部分是不表现出明显的临床症状的,除非是免疫力比较弱的狗狗,或者是比较小的幼犬才会发病。
- 吉氏巴贝斯虫 虫体很小,多呈环形。这种虫子感染引起的,基本上都会出现严重的临床症状,而恰恰我国的犬只感染的大部分是吉氏巴贝斯虫。

是什么原因引起的犬巴贝斯虫病
★第一 最重要的一种原因,是通过蜱虫传播给狗狗。
通俗易懂得传播过程:
蜱虫把带有这种寄生虫的幼虫,在吸血的时候带入狗狗的血液,然后这种幼虫进入狗狗的红细胞开始生长,然后繁殖越来越多,蜱虫在吸了这个有寄生虫的血液在咬别的狗的时候又传染给了别的狗狗。
★狗狗一般被蜱虫叮咬后12天左右开始发病!
★第二 就是狗和狗之间传播的方式,比如打架彼此受伤,某一只受伤的狗狗沾到了另一只被寄生虫感染的血液,这样就出现了交叉感染。
★第三 输血!现在宠物的医疗环境不断在提升,输血在宠物治疗中也被开展运用,比如细小拉血后期,受伤或者手术失血过多,都会通过输血来挽救性命,但是有的宠物医院在配血时候不做血液寄生虫筛查(尤其是一些隐性感染的犬只)很容易导致交叉感染。
★第四 胎盘传播 (母狗怀孕后生小狗直接传播给小狗)
据研究表面除了第一种蜱虫直接传播以外,其它几种方式引起的犬巴贝斯虫病,会有一定的耐药性,在治疗上会更难治一些。

感染犬巴贝斯虫病后狗狗有哪些症状呢?
- 比较轻的初期症状: 消瘦、食欲不好、精神也不好、喜欢睡觉、感觉身体比较没力气、站不稳、呼吸好像喘不上气来(这个时期大部分宠物主人很难发现)。
- 重度症状:体温高烧不退、无法站立、或者摇摇欲坠、尿的颜色呈茶褐色、厉害的甚至是酱油色,眼结膜发白、黄疸、口腔黏膜苍白、腹围增大、呕吐、呼吸困难等。
- 肉眼不可见的症状:血小板减少、贫血、肝脏、肾脏受损严重、脾脏肿大、血红蛋白尿等。
我们如何确定狗狗患了犬巴贝斯虫病?
主人篇:
- 最近有经常外出遛狗,尤其是在草丛边,有水的地方。
- 在狗狗身上发现过蜱虫,或者蜱虫叮咬的痕迹。
- 有莫名的高烧,查不到原因,也没有其它呼吸道感染症状。
- 有发现狗狗身上软,站立不稳,四肢无力。
- 狗狗尿尿的颜色是深红色或者是酱油色(这是一个特别的症状,很多宠物主人都是发现这个症状才去宠物医院,但是这时候狗狗已经出现溶血现象了,情况已经比较严重了。)

耳朵上的蜱虫,清晰可见
宠物医院篇
结合宠物主人的叙述症状,配合实验室检查可以确诊。
采血——做血涂片——染色——在显微镜下就可以发现红细胞中的虫体。
感染犬巴贝斯虫后需要做那些相关检查?
根据不同病情需要做
- 血常规检查(分析狗狗的贫血和炎性程度)
- 生化检查(分析狗狗的肝脏,胆,肾脏的损害程度,和预后判断)
- b超或者x光检查(判断肝脏,脾脏的肿大程度,以及有没有腹水)
- 尿常规检查(配合生化分析狗狗的肾脏情况,以及判断狗狗蛋白尿的严重程度)
图片来源网络
如何治疗犬巴贝斯焦虫病?
目前全球没没有统一的治疗标准,各个地区用药有一定区别,目前我国的治疗犬巴贝斯焦虫病主要以这些方式。
★第一 阿托伐醌和阿奇霉素联和用药。在这个联和用药的同时最好是配合多脂食物(比如肉类,奶,蛋类)一起用,可以最大化阿托伐醌的效果,同时又可以减轻肠胃负担。
★它们联和用药的副作用一般是胃肠道毒性,所以在用药期间一定注意狗狗消化道问题。
第二 三氮脒又叫血虫净,也是宠物医院常用的一种药,但是目前研究表明三氮脒无法完全清除犬吉氏巴贝斯虫,容易复发。
★这种药的副作用比较大,脑毒性,肝毒性,和注射部位坏死,在用药期间一定要密切检测狗狗的肝肾指标和身体情况。

图片来源网络
★第三 输血 对于有些溶血比较严重的,贫血特别厉害的,以及引起呼吸困难的可以尝试输血治疗+驱虫
★第四 对症治疗,保肝,支持治疗
★第五 补血(口服补血药,配合升红细胞药物同时使用)
★目前没有报道有任何药物可以完全根除犬巴贝斯焦虫,如果没有症状是不建议做治疗的。
该病目前如果主人配合治疗,送到宠物医院及时的话治愈率能达到百分之九十多,但是治愈后狗狗还继续携带病原。
★提醒宠物主人如果狗狗出现类似于巴贝斯虫感染的症状后,一定要去比较大一点的正规宠物医院治疗,因为这种疾病的特殊性,小的宠物医院可能因为化验手段单一,治疗经验不足,以及药物储备比较缺,可能会出现误诊和耽误治疗。
★需要宠物主人注意的是该病在治愈后的1-3个月都有复发的几率,所以在治愈后大家一定按时间定时体检。

如何预防犬巴贝斯焦虫病?
敲黑板,划重点。
★驱虫、驱虫、驱虫,重要的事情说三遍。目前可以预防犬巴贝斯焦虫病的有效方法是,驱体外寄生虫,预防蜱虫叮咬感染。(同时可以预防皮肤病)
第一 按宠物医生提供的建议给狗狗滴体外驱虫药。 第二 减少去野外树从和草丛,尤其是小池塘边的草地. 第三 如果是去郊游,体外寄生虫药效快到的时候,可以提前再加强一次,回来后注意检查狗狗的身上有没有蜱虫。

提醒大家:建议选用进口体外驱虫药,目前5块钱左右的驱虫药是杀不死蜱虫的,但是可以驱跳蚤虱子。
虽然这个犬巴贝斯焦虫病不是很多,但是目前的报道显示都是在增长,所以大家别存在侥幸心理,提前做好预防,听到宠物医生的驱虫碎碎念别在不厌其烦,其实他自己也烦自己的碎碎念,但是为了汪星人的生命安全,咱们宠物主人就忍了吧
参考文献:李慧,侠娄威,李格宾 (中国农业大学动物医院),宠物医师,2018.﹝6﹞﹝3﹞64-66 权中会,魏莉,赵献军等,西安地区犬吉氏巴贝斯虫病的诊断与治疗。中国兽医杂志,2012﹝04﹞64-65
#养宠大机密# #好好宠它#